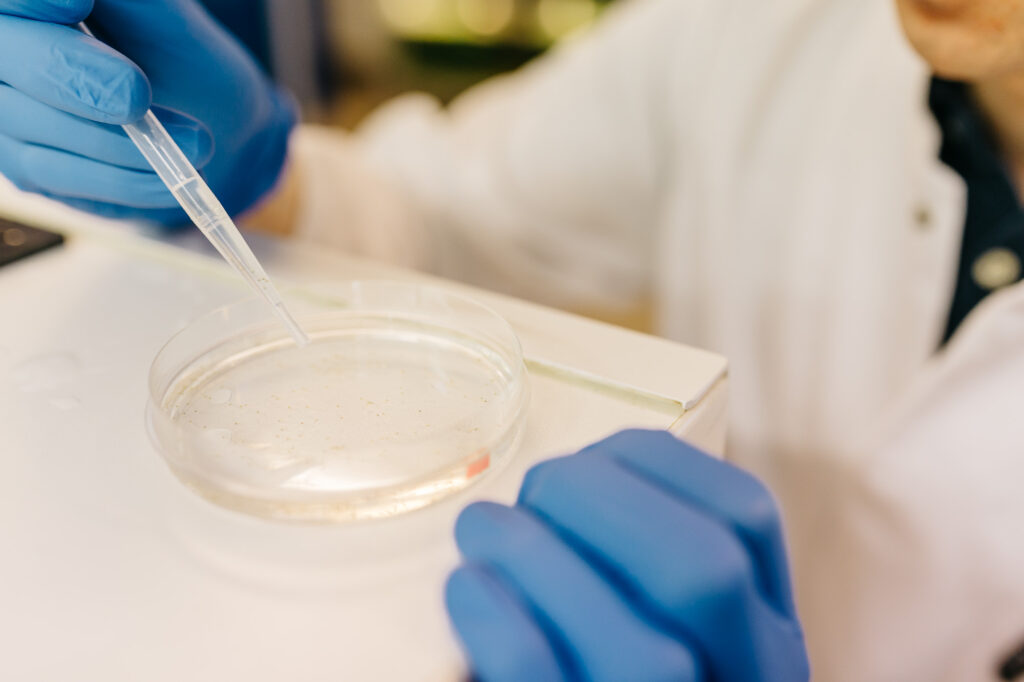

Greifswalder Nachwuchswissenschaftler fährt zum Nobelpreisträgertreffen
Für Florian Siegerist war die Einladung nach Lindau eine große Überraschung. „Ich fühle mich sehr geehrt, dass ich zum jetzigen Zeitpunkt meiner Laufbahn am Nobelpreisträgertreffen teilnehmen darf, denn ich werde erst im Herbst mein 2. Staatsexamen ablegen“, freut sich der junge Doktorand und Deutschlandstipendiat. Im Rahmen des Gerhard-Domagk-Promotionsstipendiums konnte er seine Doktorarbeit bereits nach dem 1. Staatsexamen fertigstellen. Sein Schwerpunkt ist die Nierenforschung. Für seine Doktorarbeit hat er die glomeruläre Filtrationsbarriere der Nieren von Zebrafischlarven untersucht. Als Mitglied der Arbeitsgruppe von Prof. Dr. rer. nat. Nicole Endlich wendet Florian Siegerist in seiner Forschung vor allem die Super Resolution Mikroskopie an. Im Super Resolution Mikroskop können mittels Lichtmikroskopie Strukturen dargestellt werden, die vorher nicht denkbar waren. Mit dem Einsatz in der Nierenforschung stellt diese Technologie ein Alleinstellungsmerkmal für die Greifswalder Universitätsmedizin dar. Die Erfinder der Technologie wurden 2014 mit dem Nobelpreis für Chemie ausgezeichnet. Einen von ihnen, den Physiker Stefan Hell, wird Florian Siegerist nun persönlich in Lindau treffen. Florian Siegerists berufliches Ziel ist es, als forschender Arzt tätig zu sein. Er hofft daher, in Lindau nicht nur einen spannenden Austausch mit anderen jungen Forschern und Nationen zu erleben, sondern vielleicht auch die eine oder andere Forschungskooperation anzuregen.
https://nachrichten.idw-online.de/2018/06/15/zwei-greifswalder-nachwuchswissenschaftler-fahren-zum-nobelpreistraegertreffen